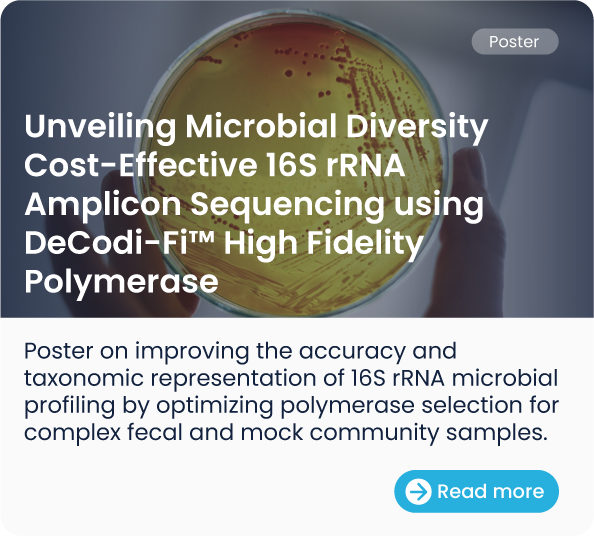
Mesa de trabajo 8

DeCodi-Fi™
Polimerasa de Alta Fidelidad
Lecturas más largas.
Muestras más complejas.
Flujos de trabajo más rápidos.
DeCodiFi™
Polimerasa de Alta Fidelidad
Lecturas más largas. Muestras más complejas. Flujos de trabajo más rápidos.
Desarrollados sobre la misma base DeCodiFi™, adaptada a diferentes necesidades.
Beneficios de DeCodiFi™
DeCodiFi™ es una polimerasa de alta fidelidad diseñada para la amplificación precisa y eficiente de fragmentos largos y matrices complejas. Ofrece una exactitud excepcional, capacidad de amplificación de largo alcance, bajo sesgo de amplificación, rendimiento rápido en ciclos de PCR y resultados confiables incluso a partir de bajas cantidades de ADN en diversas aplicaciones de PCR.
Características principales de nuestro portafolio:
-
Alta fidelidad: 60 % menos tasa de error.
-
Ciclado rápido: Tiempos de extensión <15 seg/kb.
-
Bajo input: Amplificación confiable desde tan solo 5 pg de ADN.
-
Alto rendimiento y bajo sesgo: Alta recuperación de ADN y amplificación consistente.
-
Tolerancia a uracilo: Optimizada para flujos de trabajo de epigenética y NGS.
Beneficios de DeCodi-Fi™
DeCodi-Fi™ es una ADN polimerasa de alta fidelidad diseñada para la amplificación precisa y eficiente de fragmentos largos y matrices complejas. Ofrece una exactitud excepcional, capacidad de amplificación de largo alcance, bajo sesgo de amplificación, rendimiento rápido en ciclos de PCR y resultados confiables incluso a partir de bajas cantidades de ADN en diversas aplicaciones de PCR.
Características principales de nuestro portafolio:
-
Alta fidelidad: 60 % menos tasa de error.
-
Ciclado rápido: Tiempos de extensión <15 seg/kb.
-
Bajo input: Amplificación confiable desde tan solo 5 pg de ADN.
-
Alto rendimiento y bajo sesgo: Alta recuperación de ADN y amplificación consistente.
-
Tolerancia a uracilo: Optimizada para flujos de trabajo de epigenética y NGS.

DeCodi‑Fi™
High‑Fidelity PCR Kit
Un formato flexible basado en componentes, diseñado para aplicaciones de PCR de ultra largo alcance y alta precisión. Incluye reactivos por separado y dos buffers: un Buffer 5× High-Fidelity (GC/AT balanceado) y un Buffer 5× GC-rich (para blancos ricos en GC).

DeCodi‑Fi™
All‑in‑One Mix
Mezcla maestra 2× lista para usar para amplificación de ultra largo alcance con alta fidelidad, que contiene polimerasa hot-start, buffer, dNTPs, MgCl₂ y estabilizadores. Diseñada para una preparación simplificada y alta reproducibilidad.

DeCodi‑Fi™
Long&Complex
Diseñada para matrices largas y estructuralmente complejas, incluidas regiones ricas en GC y secuencias repetitivas. Permite una amplificación confiable y de bajo sesgo de fragmentos extensos requeridos en secuenciación de lectura larga, síntesis de ADN y ensamblajes genómicos complejos.

DeCodi‑Fi™
Plant Direct
Optimizada para PCR directa a partir de material vegetal rico en inhibidores y extractos crudos, simplificando los flujos de trabajo sin comprometer la fidelidad.

DeCodi‑Fi™
Blood Direct
Optimizada para PCR directa a partir de sangre, con tolerancia a inhibidores y alto desempeño con bajo input de ADN. Compatible con sangre fresca, preservada (EDTA/citrato/heparina) o seca.

DeCodiFi™
All-In-One Mix
Formato flexible basado en componentes para aplicaciones de PCR de alta fidelidad y ultra larga. Incluye la Polimerasa Hot-Start de Alta Fidelidad por separado y dos buffers especializados 5× (High Fidelity y GC-rich), además de dNTPs y MgCl₂, para una máxima optimización.

DeCodiFi™
High‑Fidelity PCR Kit
Mezcla maestra 2× lista para usar para amplificación de ultra largo alcance con alta fidelidad, que contiene polimerasa hot-start, buffer, dNTPs, MgCl₂ y estabilizadores. Diseñada para una preparación simplificada y alta reproducibilidad.

DeCodiFi™
Long&Complex
Diseñada para matrices largas y estructuralmente complejas, incluidas regiones ricas en GC y secuencias repetitivas. Permite una amplificación confiable y de bajo sesgo de fragmentos extensos requeridos en secuenciación de lectura larga, síntesis de ADN y ensamblajes genómicos complejos.

DeCodiFi™
Plant Direct
Optimizado para PCR directa a partir de extractos crudos de plantas, permitiendo una amplificación confiable incluso en muestras con altos niveles de inhibidores, y simplificando el flujo de trabajo sin comprometer la fidelidad.

DeCodiFi™
Blood Direct
Optimizada para PCR directa a partir de sangre, con tolerancia a inhibidores y alto desempeño con bajo input de ADN. Compatible con sangre fresca, preservada (EDTA/citrato/heparina) o seca.
Explora el portafolio completo de DeCodiFi™ Polimerasa de Alta Fidelidad
TESTIMONIOS
DeCodiFi™ genera productos más homogéneos, requiere menos molde para amplificar y también necesita tiempos de extensión más cortos en cada ciclo de amplificación. Por lo tanto, es más eficiente y tiene actividad correctora (proofreading) que permite generar productos más homogéneos.
Carlos Loncoman, PhD
Facultad de Ciencias Veterinarias | Universidad Austral de Chile
Acabo de probar DeCodiFi™ y la comparé con la enzima que utilizo habitualmente en el laboratorio para la clonación. El rendimiento (cantidad de producto) es mayor y, sin duda, puedo decir que me gusta el producto porque es muy sencillo y rápido de trabajar, a la vez que me da la seguridad de que se trata de una enzima de alta fidelidad. El kit es muy fácil de usar, ya que todo viene listo para usar, lo que resulta realmente cómodo.
Cristian Droppelmann, PhD
Molecular Medicine Group | The University of Western Ontario
Quiero destacar la rapidez de la PCR: acorta el tiempo de reacción en unos 20-30 minutos. El rendimiento del producto de PCR es estupendo, lo que facilita la identificación del fragmento deseado. Estoy muy satisfecho con DeCodiFi™. Una de las enfermedades que estudio implica un gen candidato con alto contenido de GC y pseudogenes, lo que hace que la PCR sea todo un reto. Trabajo con cantidades limitadas de ADN y aún así consigo altos rendimientos del producto deseado. Cuando se trata de muestras de pacientes, donde el material es escaso, eso supone una gran ventaja.
Paola Krall, PhD.
Facultad de Medicina | Universidad de Chile
La enzima de Kura Biotech es de excelente calidad y supera a muchas de las opciones disponibles actualmente en el mercado. El objetivo del experimento era generar un plásmido que codificara una proteína truncada mediante la técnica de PCR solapada. Los resultados con DeCodiFi™ fueron muy positivos: conseguimos generar correctamente el plásmido deseado y las PCR fueron rápidas y consistentes. No se observaron errores ni productos aberrantes en ningún momento del proceso.
Ignacio Valencia
Researcher | Platech Company
He evaluado exhaustivamente la polimerasa DeCodiFi™. En amplificación de PCR largos, demuestra tanto un mejor rendimiento como una amplificación más rápida en comparación con nuestras polimerasas para PCR largo actuales de Promega y Emerald. Sus ventajas son particularmente evidentes en aplicaciones de secuenciación de lectura larga de ADNc. En nuestro flujo de trabajo, amplificamos transcritos de ARNm de longitud completa, centrándonos en genes de baja abundancia, largos y complejos. Al utilizar DeCodiFi™, pudimos reducir nuestro protocolo de laboratorio de dos días a un solo día debido a su alta velocidad de amplificación, lo cual es especialmente valioso en entornos donde el tiempo es un factor crítico. Además, DeCodiFi™ casi duplicó nuestra profundidad de secuenciación en comparación con NEB LongAmp. Más importante aún, permitió la recuperación completa de lecturas de transcritos de longitud larga, lo que anteriormente había sido un desafío obtener. En general, el uso de DeCodiFi™ ha mejorado significativamente la calidad y la eficiencia de nuestros experimentos de secuenciación de lectura larga de ADNc.
Maren Später
PhD Candidate | Sanobis GmbH





¿Listo para comenzar?
Nuestro equipo técnico está preparado para ayudarte a encontrar el producto ideal para tu tipo de muestra específico.
¿Listo para comenzar?
Nuestro equipo técnico está preparado para ayudarte a encontrar el producto ideal para tu tipo de muestra específico.